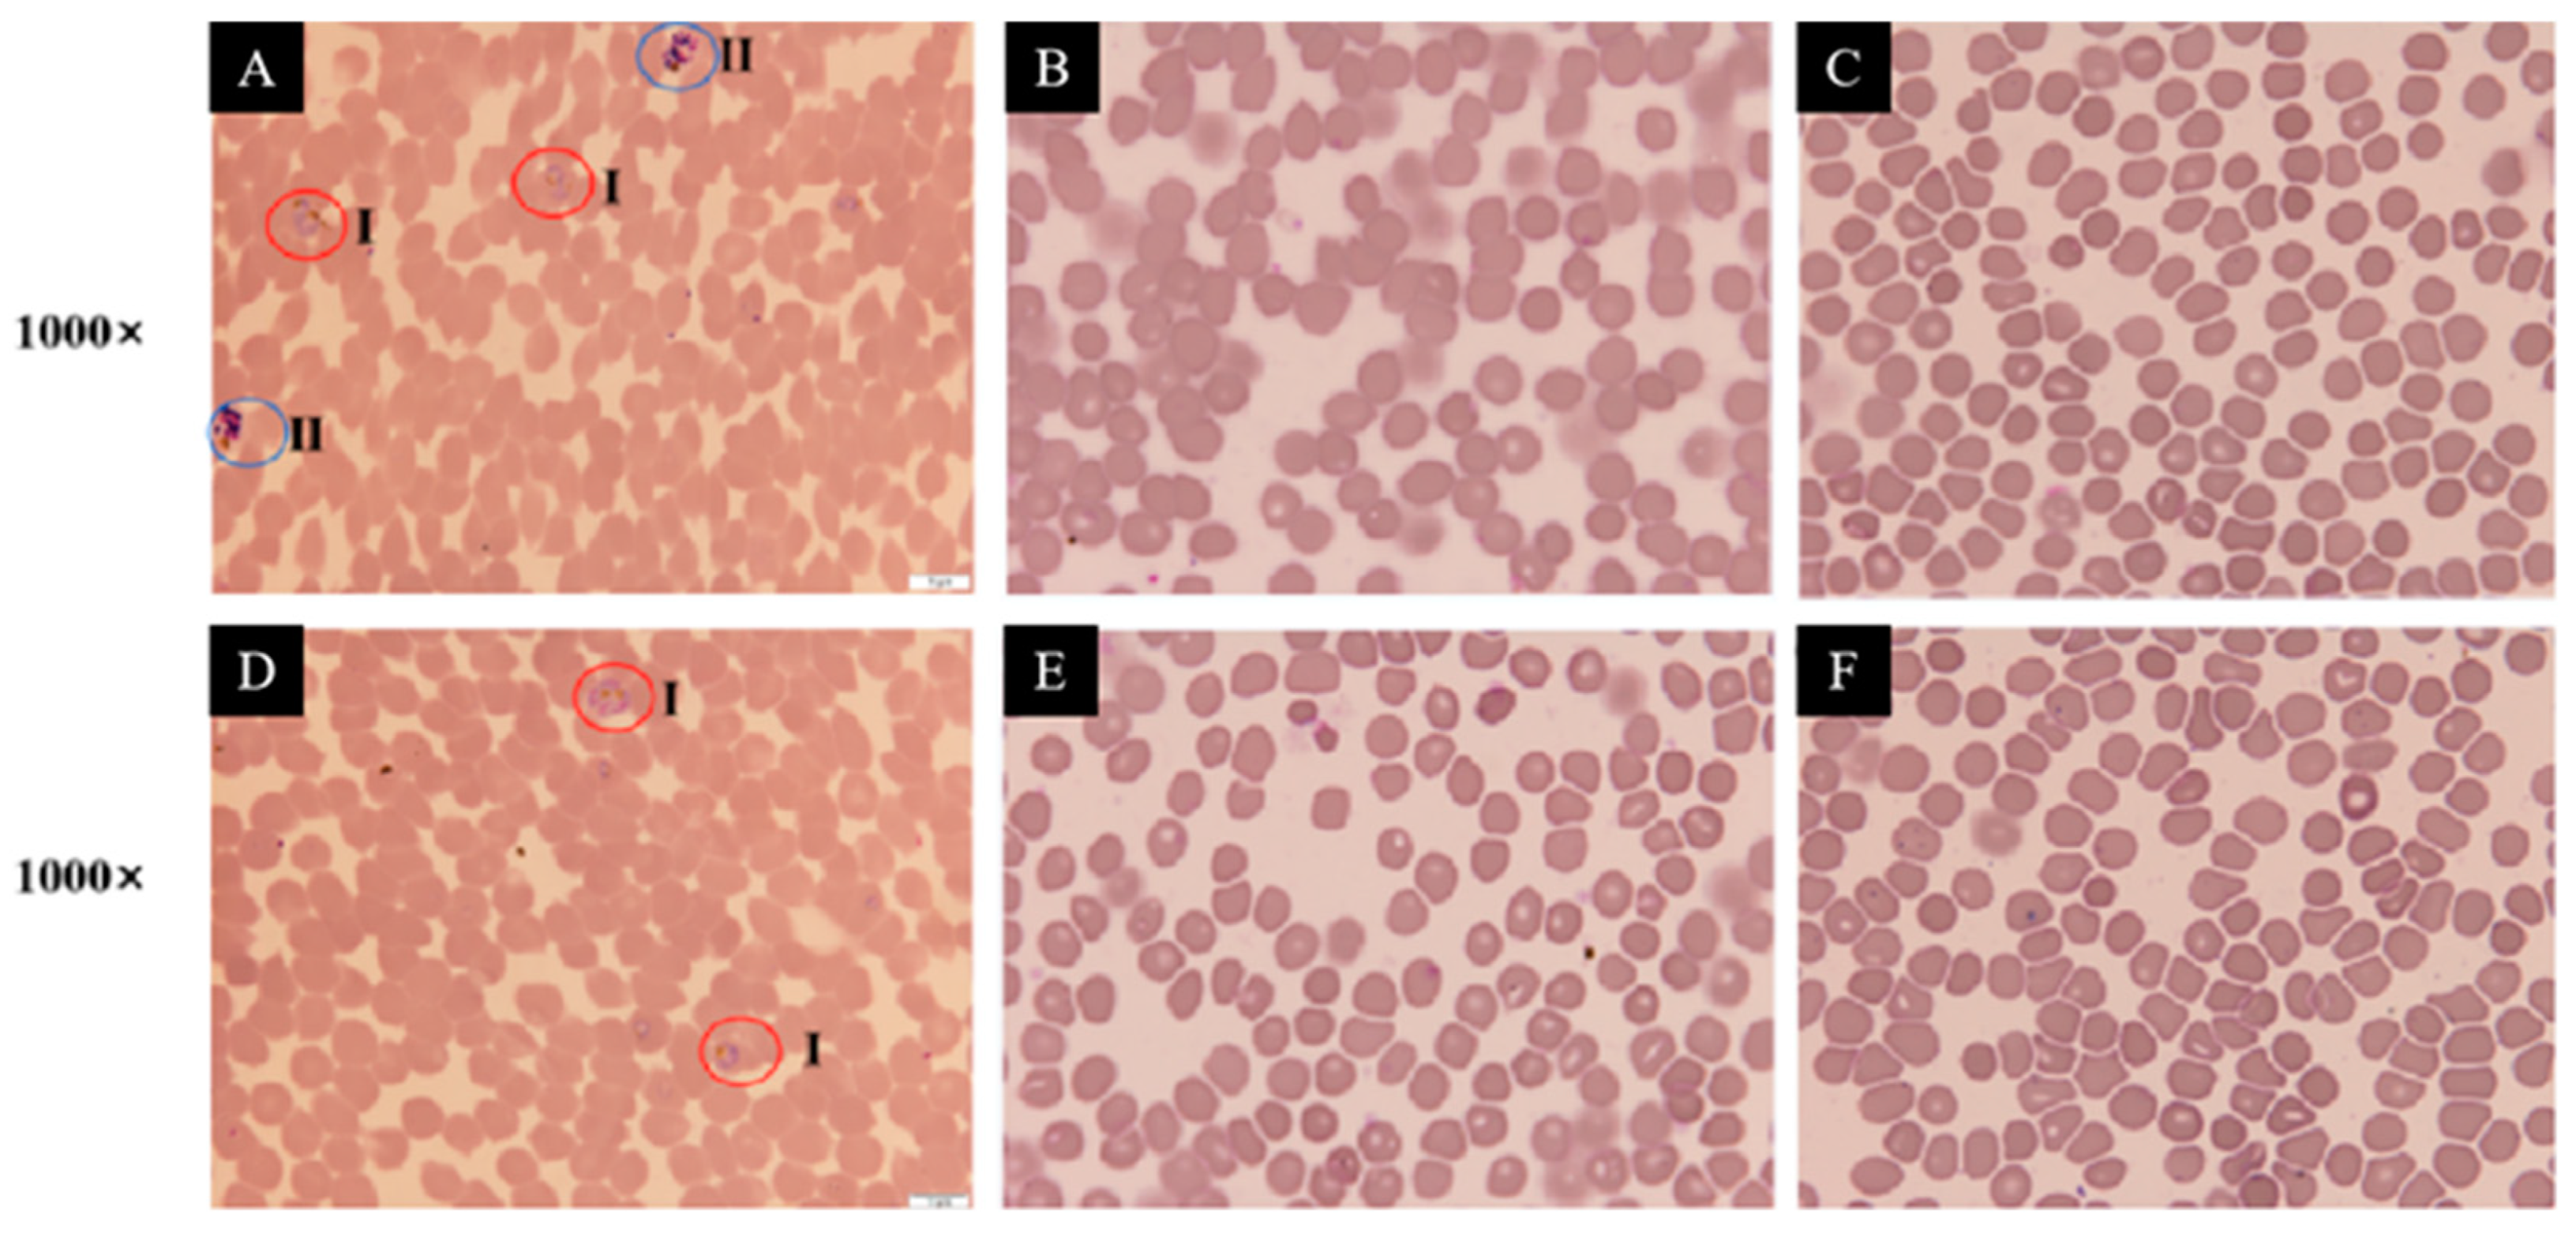
Jof 10 00736 g005

Diversity and Anti-Infectious Components of Cultivable Rhizosphere Fungi Derived from Three Species of Astragalus Plants in Northwestern Yunnan, China
Abstract
1. Introduction
2. Materials and Methods
2.1. Rhizosphere Soil Samples Collection
2.2. Isolation and Identification of Fungi
2.3. Fermentation and Extraction
2.4. Antibacterial Bioassay
2.5. Antimalarial Bioassay (In Vitro)
2.6. Isolation and Structural Elucidation of Secondary Metabolites from Aspergillus calidoustus AA12
2.7. Scanning Electron Microscopic (SEM) Observation
2.8. Nucleotide Sequence Accession Number
3. Results and Discussion
3.1. Diversity of Cultivable Fungi in the Rhizosphere Communities of Three Species of Astragalus Plants
3.2. Anti-Infectious Potential of Isolated Fungi
3.3. Structural Elucidation and Anti-Infective Activity of the Isolated Natural Products
4. Conclusions
Supplementary Materials
Author Contributions
Funding
Institutional Review Board Statement
Informed Consent Statement
Data Availability Statement
Acknowledgments
Conflicts of Interest
References
- Philippot, L.; Raaijmakers, J.M.; Lemanceau, P.; van der Putten, W.H. Going back to the roots: The microbial ecology of the rhizosphere. Nat. Rev. Microbiol. 2013, 11, 789–799. [Google Scholar] [CrossRef] [PubMed]
- Chen, D.; Zeng, J.; Wan, X.; Wang, Y.; Lan, S.; Zou, S.; Qian, X. Variation in community structure of the root-associated fungi of Cinnamomum camphora forest. J. Fungi 2022, 8, 1210. [Google Scholar] [CrossRef] [PubMed]
- Su, Y.; Yang, W.; Wang, R.; Zhang, H.; Meng, J.; Jing, H.; Zhang, G.; Wang, J.; Guo, L.; Gao, W. ZnO-S.cerevisiae: An effective growth promoter of Astragalus memeranaceus and nano-antifungal agent against Fusarium oxysporum. Chem. Eng. J. 2024, 486, 149958. [Google Scholar] [CrossRef]
- Zhang, L.; Chen, F.X.; Zeng, Z.; Xu, M.; Sun, F.; Yang, L.; Bi, X.; Lin, Y.; Gao, Y.; Hao, H.X.; et al. Advances in metagenomics and its application in environmental microorganisms. Front. Microbiol. 2021, 12, 766364. [Google Scholar] [CrossRef]
- Collaborators, A.R. Global burden of bacterial antimicrobial resistance in 2019: A systematic analysis. Lancet 2022, 399, 629–655. [Google Scholar]
- Centers for Disease Control and Prevention. Antibiotic Resistance Threats in the United States, 2019; Department of Health and Human Services, CDC: Atlanta, GA, USA, 2019.
- Tacconelli, E.; Carrara, E.; Savoldi, A.; Savoldi, A.; Harbarth, S.; Mendelson, M.; Monnet, D.L.; Pulcini, C.; Kahlmeter, G.; Kluytmans, J.; et al. Discovery, research, and development of new antibiotics: The WHO priority list of antibiotic-resistant bacteria and tuberculosis. Lancet Infect. Dis. 2018, 18, 318–327. [Google Scholar] [CrossRef] [PubMed]
- Lv, F.; Zeng, Y. Novel bioactive natural products from marine-derived Penicillium fungi: A Review (2021–2023). Mar. Drugs 2024, 22, 191. [Google Scholar] [CrossRef]
- Wang, K.L.; Dou, Z.R.; Gong, G.F.; Li, H.F.; Jiang, B.; Xu, Y. Anti-larval and anti-algal natural products from marine microorganisms as sources of anti-biofilm agents. Mar. Drugs 2022, 20, 90. [Google Scholar] [CrossRef] [PubMed]
- Wang, X.; Ji, G.; Cun, J.; Xu, P.; Wang, X.; Ren, G.; Li, W. Screening of insecticidal and antifungal activities of the culturable fungi isolated from the intertidal zones of Qingdao, China. J. Fungi 2022, 8, 1240. [Google Scholar] [CrossRef]
- Yang, X.; Yu, H.; Ren, J.; Cai, L.; Xu, L.; Liu, L. Sulfoxide-containing bisabolane sesquiterpenoids with antimicrobial and nematicidal activities from the marine-derived fungus Aspergillus sydowii LW09. J. Fungi 2023, 9, 347. [Google Scholar] [CrossRef]
- Chen, Z.; Liu, L.; Gao, C.; Chen, W.; Vong, C.; Yao, P.; Yang, Y.; Li, X.; Tang, X.; Wang, S.; et al. Astragali radix (Huangqi): A promising edible immunomodulatory herbal medicine. J. Ethnopharmacol. 2020, 258, 112895. [Google Scholar] [CrossRef] [PubMed]
- Ding, J.J.; Zhou, G.J.; Chen, X.J.; Xu, W.; Gao, X.M.; Zhang, Y.Z.; Jiang, B.; Li, H.F.; Wang, K.L. Analysis of microbial diversity and community structure of rhizosphere soil of three Astragalus species grown in special high-cold environment of northwestern Yunnan, China. Microorganisms 2024, 12, 539. [Google Scholar] [CrossRef] [PubMed]
- Dou, Z.R.; Zhang, F.; Zhou, G.J.; Gong, G.F.; Ding, J.J.; Fan, X.H.; Jiang, B.; Wang, K.L. Varicosporellopsis shangrilaensis sp. nov. (Nectriaceae, Hypocreales), a new terricolous species isolated from the rhizosphere soil of Astragalus polycladus in northwestern Yunnan. Phytotaxa 2023, 600, 230–238. [Google Scholar] [CrossRef]
- Liu, A.; Li, Y.; Wang, Q.; Zhang, X.; Xiong, J.; Li, Y.; Lei, Y.; Sun, Y. Analysis of microbial diversity and community structure of rhizosphere soil of Cistanche salsa from different host plants. Front. Microbiol. 2022, 13, 971228. [Google Scholar] [CrossRef]
- Song, Z.M.; Zhang, J.L.; Zhou, K.; Yue, L.M.; Zhang, Y.; Wang, C.Y.; Wang, K.L.; Xu, Y. Anthraquinones as potential antibiofilm agents against methicillin-resistant Staphylococcus aureus. Front. Microbiol. 2021, 12, 709826. [Google Scholar] [CrossRef]
- Gudla, C.S.; Selvam, V.; Selvaraj, S.S.; Tripathi, R.; Joshi, P.; Shaham, S.H.; Singh, M.; Shandil, R.K.; Habib, S.; Narayanan, S. Novel baicalein-derived inhibitors of Plasmodium falciparum. Pathogens 2023, 12, 1242. [Google Scholar] [CrossRef]
- Yin, Q.; Liang, J.; Zhang, W.; Zhang, L.; Hu, Z.-L.; Zhang, Y.; Xu, Y. Butenolide, a marine derived broad-spectrum antibiofilm agent against both Gram-positive and Gram-negative pathogenic bacteria. Mar. Biotechnol. 2019, 21, 88–98. [Google Scholar] [CrossRef]
- Krijgsheld, P.; Bleichrodt, R.; Veluw, G.J.; Wang, F.; Müller, W.H.; Dijksterhuis, J.; Wösten, H.A.B. Development in Aspergillus. Stud. Mycol. 2012, 74, 1–29. [Google Scholar] [CrossRef] [PubMed]
- Maestre, F.T.; Delgado-Baquerizo, M.; Jeffries, T.C.; Eldridge, D.J.; Ochoa, V.; Gozaloa, B.; Quero, J.L.; García-Gómez, M.; Gallardof, A.; Ulrichg, W.; et al. Increasing aridity reduces soil microbial diversity and abundance in global drylands. Proc. Natl. Acad. Sci. USA 2015, 112, 15684–15689. [Google Scholar] [CrossRef]
- Zhao, D.L.; Han, X.B.; Wang, M.; Zeng, Y.T.; Li, Y.Q.; Ma, G.Y.; Liu, J.; Zheng, C.J.; Wen, M.X.; Zhang, Z.F.; et al. Herbicidal and antifungal xanthone derivatives from the alga-derived fungus Aspergillus versicolor D5. J. Agric. Food Chem. 2020, 68, 11207–11214. [Google Scholar] [CrossRef]
- Yang, X.; Liu, J.; Mei, J.; Jiang, R.; Tu, S.; Deng, H.; Liu, J.; Yang, S.; Li, J. Origins, structures, and bioactivities of secondary metabolites from marine-derived Penicillium fungi. Mini Rev. Med. Chem. 2021, 21, 2000–2019. [Google Scholar] [CrossRef] [PubMed]
- Li, Z.H.; Pu-BU, R.C.; Lv, M.L.; Wang, M.; Liu, X.Y. Species diversity of Zygomycotan fungi in the Tibet Autonomous Region. Microbiol. China 2018, 45, 1250–1261. [Google Scholar]
- Lv, M.L.; Liu, Z.; Song, Z.; Wang, Y.N.; Liu, X.Y. Diversity and distribution of culturable Mucoromycota fungi in the Greater Khinggan Mountains, China. Biodivers. Sci. 2019, 27, 821–837. [Google Scholar]
- Minnis, A.M.; Lindner, D.L. Phylogenetic evaluation of geomyces and allies reveals no close relatives of Pseudogymnoascus destructans, comb. nov., in bat hibernacula of eastern North America. Fungal Biol. 2013, 117, 638–649. [Google Scholar] [CrossRef]
- Meng, Y.; Tang, H.Y.; Shi, J.D.; Wang, D. Three fungal strains isolated from stroma of Ophiocordyceps sinensis and their culture conditions. Mycosystema 2021, 40, 1991–2007. [Google Scholar]
- Zhang, L.L. Species diversity and drought resistance of dark septate endophytes in the rhizospheres of different plants in Anxi extreme arid desert. Master’s Dissertation, Hebei university, Baoding, China, 9 June 2018. [Google Scholar]
- Varga, J.; Houbraken, J.; Van-Der-Lee, H.A.; Verweij, P.E.; Samson, R.A. Aspergillus calidoustus sp. nov., causative agent of human infections previously assigned to Aspergillus ustus. Eukaryot. Cell 2008, 7, 630–638. [Google Scholar] [CrossRef]
- Valiante, V.; Mattern, D.J.; Schüffler, A.; Horn, F.; Walther, G.; Scherlach, K.; Petzke, L.; Dickhaut, J.; Guthke, R.; Hertweck, C.; et al. Discovery of an extended austinoid biosynthetic pathway in Aspergillus calidoustus. ACS Chem. Biol. 2017, 12, 1227–1234. [Google Scholar] [CrossRef] [PubMed]
- Mo, S.; Yin, J.; Ye, Z.; Li, F.; Lin, S.; Zhang, S.; Yang, B.; Yao, J.; Wang, J.; Hu, Z.; et al. Asperanstinoids A-E: Undescribed 3,5-dimethylorsellinic acid-based meroterpenoids from Aspergillus calidoustus. Phytochemistry 2021, 190, 112892. [Google Scholar] [CrossRef]
- Zhang, S.; Mo, S.; Li, F.; Zhang, Y.; Wang, J.; Hu, Z.; Zhang, Y. Drimane sesquiterpenoids from a wetland soil-derived fungus Aspergillus calidoustus TJ403-EL05. Nat. Prod. Bioprospect 2022, 12, 27. [Google Scholar] [CrossRef]
- He, J.L.; Chen, C.J.; Liu, Y.H.; Gao, C.H.; Wang, R.P.; Zhang, W.F.; Bai, M. Austin-Type Meroterpenoids from fungi reported in the last five decades: A review. J. Fungi 2024, 10, 162. [Google Scholar] [CrossRef]
- Ding, W.; Uvarani, C.; Wang, F.; Xue, Y.; Wu, N.; He, L.; Tian, D.; Chen, M.; Zhang, Y.; Hong, K.; et al. New Ophiobolins from the deep-sea derived fungus Aspergillus sp. WHU0154 and their anti-inflammatory effects. Mar. Drugs 2020, 18, 575. [Google Scholar] [CrossRef] [PubMed]
- Trisuwan, K.; Rukachaisiriku, V.; Sukpondma, Y.; Phongpaichit, S.; Preedanon, S.; Sakayaroj, J. Furo [3,2-h]isochroman, furo [3,2-h]isoquinoline, isochroman, phenol, pyranone, and pyrone derivatives from the sea fan-derived fungus Penicillium sp. PSU-F40. Tetrahedron 2010, 66, 4484–4489. [Google Scholar] [CrossRef]
- Kuramochi, K.; Tsubaki, K. Synthesis and structural characterization of natural benzofuranoids. J. Nat. Prod. 2015, 78, 1056–1066. [Google Scholar] [CrossRef] [PubMed]
- Ogawa, A.; Murakami, C.; Kamisuki, S.; Kuriyama, I.; Yoshida, H.; Sugawara, F.; Mizushina, Y. Pseudodeflectusin, a novel isochroman derivative from Aspergillus pseudodeflectus a parasite of the sea weed, Sargassum fusiform, as a selective human cancer cytotoxin. Bioorg. Med. Chem. Lett. 2004, 14, 3539–3543. [Google Scholar] [CrossRef] [PubMed]
- Xu, X.; Guo, S.; Chen, H.; Zhang, Z.; Li, X.; Wang, W.; Guo, L. Bioassay-guided isolation and characterization of antibacterial compound from Aspergillus fumigatus HX-1 associated with Clam. 3 Biotech 2021, 11, 193. [Google Scholar] [CrossRef] [PubMed]
- Newaz, A.W.; Yong, K.; Yi, W.; Wu, B.; Zhang, Z. Antimicrobial metabolites from the indonesian mangrove sediment-derived fungus Penicillium chrysogenum sp. ZZ1151. Nat. Prod. Res. 2023, 37, 1702–1708. [Google Scholar] [CrossRef]
- Guo, L.; Wang, L.; Li, X.; Xu, X.; Guo, J.; Wang, X.; Yang, W.; Xu, F.; Li, F. Enhanced production of questin by marine-derived Aspergillus flavipes HN4-13. 3 Biotech 2020, 10, 54. [Google Scholar] [CrossRef]
- Paveenkittiporn, W.; Ungcharoen, R.; Kerdsin, A. Streptococcus agalactiae infections and clinical relevance in adults, Thailand. Diagn. Microbiol. Infect. Dis. 2020, 97, 15005. [Google Scholar] [CrossRef]
- Gonzalez-Moreno, M.; Trampuz, A.; Di-Luca, M. Synergistic antibiotic activity against planktonic and biofilm-embedded Streptococcus agalactiae, Streptococcus pyogenes and Streptococcus oralis. J. Antimicrob. Chemother. 2017, 72, 3085–3092. [Google Scholar] [CrossRef]
- Liu, X.H.; Miao, F.P.; Ming-Feng Qiao, M.F.; Robert, H.; Ji, N.Y. Terretonin, ophiobolin, and drimane terpenes with absolute configurations from an algiconus Aspergillus ustus. RSC Adv. 2013, 3, 588–595. [Google Scholar] [CrossRef]
- Arai, M.; Niikawa, H.; Kobayashi, M. Marine-derived fungal sesterterpenes, ophiobolins, inhibit biofilm formation of Mycobacterium species. J. Nat. Med. 2013, 67, 271–275. [Google Scholar] [CrossRef] [PubMed]
- Cai, R.; Jiang, H.; Mo, Y.; Guo, H.; Li, C.; Long, Y.; Zang, Z.; She, Z. Ophiobolin-type sesterterpenoids from the mangrove endophytic fungus Aspergillus sp. ZJ-68. J. Nat. Prod. 2019, 82, 2268–2278. [Google Scholar] [CrossRef] [PubMed]
- Wei, H.; Itoh, T.; Kinoshita, M.; Nakai, Y.; Kurotaki, M.; Kobayashi, M. Cytotoxic sesterterpenes, 6-epi-ophiobolin G and 6-epi-ophiobolin N, from marine derived fungus Emericella variecolor GF10. Tetrahedron 2004, 60, 6015–6019. [Google Scholar] [CrossRef]

| Species | Representative Isolates (Accession Number in GenBank) | Similarity | Number of Fungal Isolates | ||
|---|---|---|---|---|---|
| Aa | Af | Ae | |||
| Penicillium wellingtonense | AA3 (JN617713) | 100.00% | 2 | ||
| P. polonicum | AA17 (OK510248) | 99.19% | 1 | 2 | |
| P. glabrum | AE3-1 (OP179016) | 99.49% | 1 | 2 | |
| P. brevicompactum | AE7 (MT558924) | 100.00% | 1 | ||
| P. vasconiae | AF5 (OQ870819) | 98.86% | 8 | ||
| P. suaveolens | AF6 (MH864249) | 99.48% | 1 | ||
| P. thomii | AF19 (OR574374) | 99.58% | 1 | ||
| Aspergillus calidoustus | AA12 (MZ267040) | 100.00% | 3 | ||
| A. fumigatus | AA15 (MG991598) | 100.00% | 2 | 9 | 2 |
| A. niger | AE10 (OM841707) | 99.74% | 1 | ||
| A. versicolor | AF2-1 (MT582751) | 100.00% | 1 | ||
| A. tabacinus | AF16 (OK011797) | 98.68% | 2 | ||
| Mortierella alpina | AA10 (MT366045) | 100.00% | 8 | 2 | 3 |
| M.clonocystis | AA2 (LC515184) | 100.00% | 3 | ||
| M. minutissima | AF9 (MT072066) | 98.93% | 1 | ||
| M. verticillata | AF20 (MT028128) | 99.50% | 1 | ||
| Truncatella angustata | AA1-1 (MT514384) | 100.00% | 3 | ||
| Cordyceps farinosa | AA8 (MF494607) | 99.82% | 3 | ||
| Exophiala tremulae | AA21 (NR159874) | 98.84% | 1 | ||
| Beauveria pseudobassiana | AA4-1 (KT368174) | 100.00% | 1 | ||
| Samsoniella hepiali | AA16 (OL684609) | 98.91% | 2 | ||
| Cladosporium cladosporioides | AA2-1 (ON970159) | 100.00% | 1 | 2 | |
| Neonectria radicicola | AA1 (AJ875331) | 100.00% | 1 | ||
| Trichoderma atroviride | AA14 (KX379158) | 99.63% | 1 | 3 | |
| T. paraviridescens | AF8 (MN900599) | 100.00% | 1 | ||
| T. koningiopsis | AF23 (KU645324) | 99.83% | 2 | ||
| T. viride | AF29 (KU202222) | 98.71% | 1 | ||
| T. longipile | AF30 (AY737763) | 100.00% | 2 | ||
| T. longibrachiatum | AE8 (KU945846) | 99.71% | 1 | ||
| Pseudogymnoascus roseus | AA4 (KJ755524) | 100.00% | 2 | ||
| Leptosphaeria sclerotioides | AE3 (OR782803) | 99.76% | 2 | ||
| Fusarium solani | AE4-1 (KT192216) | 98.98% | 1 | ||
| Nemania diffusa | AE4 (MK336457) | 99.21% | 1 | ||
| Aporospora terricola | AE1 (KC292841) | 98.47% | 1 | ||
| Lecanicillium aphanocladii | AF15 (OR752316) | 99.32% | 1 | ||
| Umbelopsis vinacea | AF14 (KT354998) | 99.34% | 1 | ||
| U. ramanniana | AF26 (GU934569) | 98.21% | 1 | ||
| U. nana | AF31 (OR724064) | 100.00% | 1 | ||
| Fungal Strains | Methicillin-Resistant Staphylococcus aureus (MRSA) ATCC 43300 | S. aureus ATCC 25923 | S. aureus ATCC 12228 | Vancomycin-Resistant Enterococcus faecalis (VREF)ATCC 51299 | E. faecalis ATCC 29212 | E. faecium ATCC 35667 | Streptococcus agalactiae ATCC 13813 |
|---|---|---|---|---|---|---|---|
| Aspergillus calidoustus AA12 | 6.25 | 6.25 | 12.5 | 12.5 | 6.25 | 12.5 | 25 |
| A. fumigatus AA15 | 25 | 25 | 25 | 50 | 50 | 50 | 25 |
| A. tabacinus AF16 | 50 | 25 | 25 | - | - | - | 50 |
| Penicillium glabrum AE3-1 | 50 | 50 | 12.5 | - | - | - | 50 |
| P. polonicum AA17 | 50 | 50 | 50 | - | - | - | 50 |
| P. brevicompactum AE7 | 10 | 50 | 25 | - | - | - | 50 |
| P. vasconiae AF5 | - | - | - | - | - | - | 50 |
| Cordyceps farinosa AA8 | 100 | 100 | 100 | - | - | - | 50 |
| Lecanicillium aphanocladii AF15 | 25 | 50 | 50 | 50 | 50 | - | 50 |
| Umbelopsis nana AF31 | 50 | 50 | 25 | 50 | 50 | - | 50 |
| Positive control: vancomycin | 2 | 2 | 2 | - | 2 | 2 | 2 |
| Fungal Strain | Test Concentration (µg/mL) | Inhibitory Rates ± SD (%) |
|---|---|---|
| Aspergillus calidoustus AA12 | 100 | 99.78 ± 0.21 ** |
| 50 | 99.60 ± 0.29 ** | |
| A. fumigatus AA15 | 100 | 81.81 ± 1.86 * |
| 50 | 14.31 ± 0.61 * | |
| A. tabacinus AF16 | 100 | 95.60 ± 0.90 ** |
| 50 | 91.19 ± 1.02 * | |
| Penicillium glabrum AE3-1 | 100 | 29.57 ± 0.84 * |
| 50 | 0.93 ± 0.37 * | |
| P. polonicum AA17 | 100 | −51.88 ± 1.80 * |
| 50 | −32.53 ± 1.07 * | |
| P. brevicompactum AE7 | 100 | 87.95 ± 0.73 ** |
| 50 | 81.91 ± 2.30 * | |
| Cordyceps farinosa AA8 | 100 | −45.30 ± 2.00 * |
| 50 | −15.46 ± 0.67 * | |
| Positive control: chloroquine | 0.16 | 99.88 ± 0.09 ** |
| Compounds | Methicillin-Resistant Staphylococcus aureus (MRSA) ATCC 43300 | S. aureus ATCC 25923 | S. aureus ATCC 12228 | Vancomycin-Resistant Enterococcus faecalis (VREF)ATCC 51299 | E. faecalis ATCC 29212 | E. faecium ATCC 35667 | Streptococcus agalactiae ATCC 13813 |
|---|---|---|---|---|---|---|---|
| 1 | 25 | 12.25 | 12.5 | 50 | 12.5 | 25 | 6.25 |
| 2 | - | - | - | - | - | - | 100 |
| 3 | - | - | - | - | - | - | 100 |
| 4 | - | - | - | - | - | - | 50 |
| 5 | - | - | - | - | - | - | 100 |
| 6 | - | - | - | - | - | - | - |
| 7 | 100 | - | - | - | - | - | - |
| Vancomycin | 2 | 2 | 2 | - | 2 | 2 | 2 |
Disclaimer/Publisher’s Note: The statements, opinions and data contained in all publications are solely those of the individual author(s) and contributor(s) and not of MDPI and/or the editor(s). MDPI and/or the editor(s) disclaim responsibility for any injury to people or property resulting from any ideas, methods, instructions or products referred to in the content. |
© 2024 by the authors. Licensee MDPI, Basel, Switzerland. This article is an open access article distributed under the terms and conditions of the Creative Commons Attribution (CC BY) license (https://creativecommons.org/licenses/by/4.0/).
Share and Cite
Zhou, G.-J.; Xiong, W.-J.; Xu, W.; Dou, Z.-R.; Liu, B.-C.; Li, X.-L.; Du, H.; Li, H.-F.; Zhang, Y.-Z.; Jiang, B.; et al. Diversity and Anti-Infectious Components of Cultivable Rhizosphere Fungi Derived from Three Species of Astragalus Plants in Northwestern Yunnan, China. J. Fungi 2024, 10, 736. https://doi.org/10.3390/jof10110736
Zhou G-J, Xiong W-J, Xu W, Dou Z-R, Liu B-C, Li X-L, Du H, Li H-F, Zhang Y-Z, Jiang B, et al. Diversity and Anti-Infectious Components of Cultivable Rhizosphere Fungi Derived from Three Species of Astragalus Plants in Northwestern Yunnan, China. Journal of Fungi. 2024; 10(11):736. https://doi.org/10.3390/jof10110736
Chicago/Turabian StyleZhou, Guo-Jun, Wei-Jia Xiong, Wei Xu, Zheng-Rong Dou, Bo-Chao Liu, Xue-Li Li, Hao Du, Hai-Feng Li, Yong-Zeng Zhang, Bei Jiang, and et al. 2024. "Diversity and Anti-Infectious Components of Cultivable Rhizosphere Fungi Derived from Three Species of Astragalus Plants in Northwestern Yunnan, China" Journal of Fungi 10, no. 11: 736. https://doi.org/10.3390/jof10110736
APA StyleZhou, G.-J., Xiong, W.-J., Xu, W., Dou, Z.-R., Liu, B.-C., Li, X.-L., Du, H., Li, H.-F., Zhang, Y.-Z., Jiang, B., & Wang, K.-L. (2024). Diversity and Anti-Infectious Components of Cultivable Rhizosphere Fungi Derived from Three Species of Astragalus Plants in Northwestern Yunnan, China. Journal of Fungi, 10(11), 736. https://doi.org/10.3390/jof10110736
